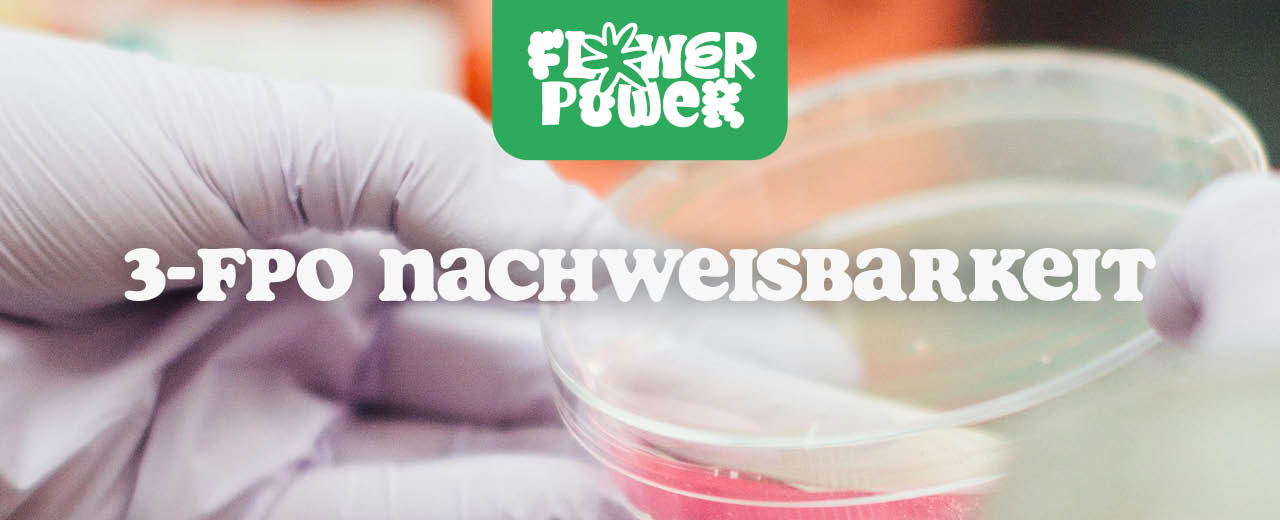
3-FPO

3-FPO Erfahrung: Wirkung, Gefühle & was Nutzer wirklich berichten
·
3-FPO ist das neue Smart-Stimulans, das Neugier und Vorsicht gleichermaßen weckt. Nutzer berichten von klarer Euphorie, Fokus und Produktivität ohne harten Crash. Erfahre, wie 3-FPO wirkt, welche Dosierungen üblich sind und wo Risiken lauern – mit echten Erfahrungswerten und wissenschaftlicher Einordnung.
Weiterlesen

Damiana (Turnera diffusa) – Wirkung, Anwendung & das Geheimnis der Liebespflanze
·
Damiana – die kleine, gelbblühende Pflanze aus Mexiko – ist seit Jahrhunderten als Aphrodisiakum, Entspannungsmittel und Stimmungsaufheller bekannt. Ihre Blätter enthalten Flavonoide, ätherische Öle und einzigartige Wirkstoffe wie Damianin, die sanft euphorisierend wirken. Ob als Tee, Vape, Extrakt oder in modernen Smartshop-Produkten – Damiana erlebt heute ein Revival. In diesem Artikel erfährst Du, wie Damiana wirkt, wie Du sie sicher einsetzt, was die Forschung sagt und welche Alternativen Du bei FlowerPower.io findest.
Weiterlesen

Kava Wirkung & Risiken erklärt – Die magische Wurzel aus dem Pazifik (2025)
·
Kava (auch Kava-Kava) ist eine traditionsreiche Wurzel aus dem Südpazifik, die heute als natürliche Alternative zu THC und CBD im Gespräch ist. Ihre Kavalactone wirken beruhigend, angstlösend und entspannend – aber nicht ohne Risiko: Leberbelastung, Dosierungsfehler und rechtliche Grauzonen machen Kava zu einer Substanz, die mit Respekt konsumiert werden sollte. In diesem Artikel erfährst Du alles über Wirkung, Anwendung, Risiken und die spannende Geschichte einer Pflanze, die zwischen Ritual, Medizin und Smartshop-Trend oszilliert.
Weiterlesen

Psychedelic Retreats – Heilung, Transformation & die neue Achtsamkeitskultur
·
Psychedelic Retreats verbinden alte Schamanenrituale mit moderner Neurowissenschaft. Erfahre, wie Psilocybin, Ayahuasca & LSD-Analoga bei Heilung, Traumabewältigung und persönlichem Wachstum helfen. Inklusive Ablauf, Sicherheit, Vorbereitung, Integration und rechtlicher Lage – seriös erklärt im FlowerPower-Stil.
Weiterlesen

1S-LSD vs. 1D-LSD – Was ist der Unterschied?
·
1S-LSD und 1D-LSD sind chemische Geschwister – aber mit klaren Unterschieden. In diesem Artikel erfährst Du alles über Struktur, Wirkung, Intensität, Nachweisbarkeit und aktuelle Rechtslage. Ideal für alle, die sich für legale LSD-Alternativen interessieren und sicher bleiben wollen.
Weiterlesen

1SB+ (1-B-LSD): Die letzte legale LSD-Alternative?
·
1S-LSD galt lange als legale Alternative zu LSD – erhältlich in Smartshops, genutzt für Forschung und Konsum. Doch inzwischen ist es in vielen Ländern verboten. In diesem Artikel erfährst Du die Hintergründe des 1S-LSD-Verbots, die internationalen Unterschiede, die Folgen für Konsumenten und welche Alternativen noch übrig bleiben.
Weiterlesen

Medizinische Pilze erklärt: Von Reishi bis Lion’s Mane – Wirkung & Anwendung
·
Medizinische Pilze begleiten die Menschheit seit Jahrtausenden – ob in der Traditionellen Chinesischen Medizin, in Ritualen indigener Völker oder heute in modernen Supplementen. In diesem Guide erfährst Du alles: Welche Pilze es gibt, wie sie wirken, was die Forschung sagt und wie Du echte Qualität erkennst. Ein tiefes Eintauchen in die faszinierende Welt von Reishi, Lion’s Mane, Cordyceps & Co. – mit klaren Tipps zur Anwendung und wissenschaftlichen Einordnung.
Weiterlesen

3,4-EtMC vs. 3-MMC: Welches Cathinon überzeugt?
·
MDMA gilt als Klassiker unter den Empathogenen – intensiv, verbindend und weltweit bekannt. Doch mit 3,4-EtMC taucht eine Research-Chemical-Alternative auf, die kürzer, leichter und weniger erforscht ist. Dieser Artikel vergleicht die beiden Substanzen im Detail: Wirkung, Dauer, Risiken, Nachweisbarkeit und Community-Erfahrungen.
Weiterlesen

3,4-EtMC vs. MDMA: Wirkung, Dauer & Risiken im Vergleich
·
MDMA gilt als Klassiker unter den Empathogenen – intensiv, verbindend und weltweit bekannt. Doch mit 3,4-EtMC taucht eine Research-Chemical-Alternative auf, die kürzer, leichter und weniger erforscht ist. Dieser Artikel vergleicht die beiden Substanzen im Detail: Wirkung, Dauer, Risiken, Nachweisbarkeit und Community-Erfahrungen.
Weiterlesen

Smartshops & Recht: Grauzonen, Gesetze und internationale Unterschiede
·
Smartshops bewegen sich oft in rechtlichen Grauzonen: Während sie in den Niederlanden weitgehend legal sind, kämpfen Betreiber in Deutschland mit strengen Gesetzen. Auch international gibt es große Unterschiede, von liberal bis restriktiv. Dieser Guide erklärt, wie Smartshops rechtlich eingeordnet werden, welche Grauzonen existieren und worauf Konsumenten achten sollten.
Weiterlesen

3,4-EtMC Konsumformen: Oral, nasal oder sublingual – was sind die Unterschiede?
·
3,4-EtMC ist ein neuartiges Cathinon-Derivat, das in der Forschung zunehmend Aufmerksamkeit erhält. Doch die Konsumform beeinflusst Wirkung, Intensität und Risiken erheblich. Oral, nasal oder sublingual – jede Methode hat ihre eigenen Vor- und Nachteile. In diesem Guide erfährst Du, wie sich die Einnahmewege unterscheiden und was sie für Forschung und Sicherheit bedeuten.
Weiterlesen

3,4-EtMC & Emotionen: Nähe, Empathie & soziale Wirkung
·
3,4-EtMC ist ein neuartiges Cathinon-Derivat, das in der Forschung besonders wegen seiner Wirkung auf Empathie und soziale Nähe im Mittelpunkt steht. Doch warum beeinflusst die Substanz unsere Gefühle so stark? In diesem Guide erfährst Du, wie 3,4-EtMC Emotionen, Gruppendynamik und Selbstwahrnehmung verändert, welche Chancen darin liegen und wo Risiken auftreten können.
Weiterlesen

3,4-EtMC Toleranz: Wie schnell passt sich der Körper an?
·
Wer 3,4-EtMC regelmäßig konsumiert, fragt sich schnell: Wie lange wirkt die Substanz zuverlässig und wann tritt Toleranz ein? Bei MDMA ist bekannt, dass schon kurze Abstände die Wirkung deutlich abschwächen. Doch wie verhält es sich bei 3,4-EtMC? In diesem Artikel erfährst Du alles über Toleranzentwicklung, Cross-Toleranz und Strategien zur Risikominimierung.
Weiterlesen

3,4-EtMC Langzeitfolgen: Was wir wirklich wissen – und was offen bleibt
·
3,4-EtMC ist ein neuartiges Cathinon-Derivat, das der Forschung spannende Einblicke in Empathie und soziales Verhalten ermöglicht. Doch welche Langzeitfolgen bringt der Konsum mit sich? Während Studien noch fehlen, geben Erfahrungsberichte erste Hinweise. In diesem Artikel erfährst Du alles über mögliche Risiken, Vergleiche mit MDMA und offene Fragen.
Weiterlesen

3,4-EtMC Mischkonsum: Gefährliche Kombinationen und sichere Ansätze
·
Mischkonsum ist einer der größten Risikofaktoren bei Research Chemicals. Auch bei 3,4-EtMC kann die Kombination mit Alkohol, MDMA oder anderen Substanzen gefährlich sein. Dieser Guide erklärt, welche Wirkungen sich gegenseitig verstärken, wo ernste Gesundheitsrisiken entstehen und wie sichere Ansätze im Research-Kontext aussehen können.
Weiterlesen

3,4-EtMC erklärt: Der große Guide zu Wirkung, Anwendung & Forschung
·
3,4-EtMC ist ein neuartiges Cathinon-Derivat, das in der Forschung besonderes Interesse weckt – vor allem wegen seiner Nähe zu MDMA und MDA. Doch was steckt wirklich dahinter? In diesem Guide erfährst Du alles über Wirkung, Anwendung im Research-Kontext, Nebenwirkungen, rechtliche Fragen und Nachweisbarkeit. Der umfassende Überblick für Einsteiger und Experten.
Weiterlesen

1S-LSD Verbot: Hintergründe, Folgen & was Konsumenten jetzt wissen müssen
·
1S-LSD galt lange als legale Alternative zu LSD – erhältlich in Smartshops, genutzt für Forschung und Konsum. Doch inzwischen ist es in vielen Ländern verboten. In diesem Artikel erfährst Du die Hintergründe des 1S-LSD-Verbots, die internationalen Unterschiede, die Folgen für Konsumenten und welche Alternativen noch übrig bleiben.
Weiterlesen

1S-LSD Toleranz: Wie schnell passt sich der Körper an?
·
Wer 1S-LSD regelmäßig konsumiert, stellt schnell die Frage: Wie schnell gewöhnt sich der Körper daran? Die Toleranzentwicklung bei Psychedelika ist ein gut dokumentiertes Phänomen – doch für 1S-LSD fehlen Studien. Dieser Artikel erklärt, was wir aus LSD-Forschung und Nutzererfahrungen ableiten können, wie Cross-Toleranz funktioniert und wie Pausen den Effekt erhalten.
Weiterlesen

1S-LSD Langzeitfolgen: Was wir wirklich wissen (und was offen bleibt)
·
1S-LSD wird oft als legale Alternative zu LSD verkauft. Doch welche Langzeitfolgen bringt der Konsum wirklich mit sich? Während wissenschaftliche Studien noch spärlich sind, liefern Erfahrungsberichte erste Hinweise. In diesem Artikel erfährst Du, welche psychischen und körperlichen Risiken bekannt sind – und wo es noch große Wissenslücken gibt.
Weiterlesen

Research Chemicals erklärt: Chancen, Risiken und die Rolle von Smartshops
·
Research Chemicals (RCs) sorgen seit Jahren für Diskussionen: Sind sie legale Alternativen oder riskante Experimente? In diesem Artikel erfährst Du, was Research Chemicals sind, wie sie entstanden sind, welche Chancen und Risiken sie bergen und welche Rolle Smartshops bei ihrer Verbreitung spielen. Ein tiefer Einblick in eine komplexe Szene.
Weiterlesen

1S-LSD Mischkonsum: Gefährliche Kombinationen und sichere Ansätze
·
Mischkonsum mit 1S-LSD ist ein sensibles Thema: Viele Nutzer fragen sich, ob die Kombination mit Cannabis, Alkohol oder anderen Substanzen gefährlich ist. In diesem Artikel erfährst Du, welche Mixes riskant sind, welche als sicherer gelten und wie Harm-Reduction beim Mischkonsum von 1S-LSD aussieht.
Weiterlesen

1S-LSD Microdosing: Chancen, Erfahrungen & Forschung
·
Microdosing mit 1S-LSD gilt als Trend für Kreativität, Fokus und persönliche Entwicklung. Viele Nutzer berichten von gesteigerter Klarheit und emotionalem Gleichgewicht – ohne die intensiven Trips hoher Dosen. Doch was ist dran? In diesem Artikel erfährst Du alles über Chancen, Erfahrungen aus der Szene und den Stand der Forschung.
Weiterlesen

4-Pro-MET Konsumformen: Oral, nasal oder sublingual – was sind die Unterschiede?
·
Die Konsumform entscheidet bei 4-Pro-MET stark über Wirkung, Dauer und Intensität. Ob oral, nasal oder sublingual – jede Methode hat eigene Vor- und Nachteile. Dieser Artikel zeigt Dir, wie sich die Einnahmearten unterscheiden, welche Risiken bestehen und welche Form für welche Situation am besten geeignet ist.
Weiterlesen

Smartshop-Zukunft: Was kommt nach HHC & 1S-LSD?
·
Die Smartshop-Welt ist ständig in Bewegung: Auf HHC folgte THC-P, auf 1cP-LSD kam 1S-LSD. Doch was kommt als Nächstes? In diesem Artikel werfen wir einen Blick in die Zukunft der Smartshop-Szene. Wir analysieren neue Cannabinoide, LSD-Derivate, mögliche Trendprodukte und zeigen, wie sich die Szene in den nächsten Jahren entwickeln könnte.
Weiterlesen

Smartshop-Kultur: Wie sich die Szene seit den 2000ern verändert hat
·
Die Smartshop-Szene hat sich seit den 2000ern stark verändert: Von verrauchten Headshops mit Spice und Salvia bis hin zu modernen Online-Stores mit CBD, HHC und 1S-LSD. Gesetze, Trends und neue Zielgruppen haben die Kultur geprägt – zwischen Underground, Lifestyle und Mainstream. Hier erfährst Du, wie sich die Szene entwickelt hat und wohin sie geht.
Weiterlesen

4-Pro-MET Toleranzentwicklung: Wie schnell gewöhnt sich der Körper?
·
Wer 4-Pro-MET regelmäßig konsumiert, merkt schnell: Die Wirkung nimmt ab. Doch wie stark entwickelt sich Toleranz wirklich, und was bedeutet das für die Praxis? In diesem Artikel erfährst Du, wie sich der Körper an 4-Pro-MET gewöhnt, welche Rolle Cross-Toleranz mit LSD und Psilocybin spielt und wie Pausen helfen können.
Weiterlesen

4-Pro-MET Geschichte & Entdeckung: Von Shulgin bis Heute
·
4-Pro-MET hat eine spannende Reise hinter sich: Von Alexander Shulgins ersten Synthesen und Notizen in den 1980ern bis zur heutigen Diskussion über Psychedelika in Forschung und Subkultur. Erfahre, wie die Substanz entdeckt wurde, warum sie bis heute kaum erforscht ist und welche Chancen & Risiken Nutzer und Forscher sehen.
Weiterlesen

Woran erkennt man qualitatives NB-DMT?
·
Woran erkennt man qualitatives NB-DMT? Dieser Artikel erklärt, wie du reines NB-DMT identifizierst, welche Eigenschaften wichtig sind und wie du Verunreinigungen vermeidest.Viel Spaß beim Lesen!
Weiterlesen

Wie konsumiert man NB-DMT?
·
Wie konsumiert man NB-DMT? Dieser Artikel erklärt Methoden, Dosierungen, Risiken und rechtliche Aspekte – für eine sichere und kontrollierte Anwendung.
Viel Spaß beim Lesen!
Weiterlesen

4-Pro-MET Mischkonsum: Gefährliche Kombinationen und sichere Ansätze
·
Mischkonsum mit 4-Pro-MET klingt für viele nach einem spannenden Experiment – birgt aber oft unterschätzte Risiken. Welche Substanzen sich gefährlich verstärken, wo Wechselwirkungen auftreten und wie Du Dich schützen kannst, erfährst Du hier im Detail. Von Alkohol bis Cannabis, von Stimulanzien bis Psychedelika: Wir zeigen Dir die Chancen, die Gefahren und wie ein bewusster Umgang aussieht.
Weiterlesen

Studien zu NB-DMT
·
Studien zu NB-DMT zeigen: Die Substanz ist sanft, kontrollierbar und hat therapeutisches Potenzial. Erfahre alles über aktuelle Forschung und Zukunftstrends.
Viel Spaß beim Lesen!
Weiterlesen

NB-DMT Herstellung
·
Die NB-DMT Herstellung erfolgt synthetisch im Labor. Erfahre alles über Ausgangsstoffe, Reinheit, rechtliche Aspekte und warum Qualität entscheidend ist.
Viel Spaß beim Lesen!
Weiterlesen

4-Pro-MET & Spiritualität: Zwischen mystischer Erfahrung und moderner Selbstfindung
·
4-Pro-MET wird nicht nur als Research Chemical gehandelt, sondern zunehmend auch als Werkzeug der modernen Spiritualität diskutiert. Zwischen mystischer Erfahrung, innerer Selbstfindung und der Suche nach Klarheit bewegt sich ein Spannungsfeld, das sowohl faszinierend als auch riskant sein kann. Der Artikel beleuchtet die Hintergründe, mögliche Chancen und die offenen Fragen.
Weiterlesen

3-FPO Langzeitfolgen: Chancen, Risiken und offene Fragen
·
Welche Langzeitfolgen hat 3-FPO wirklich? Erfahre Chancen, Risiken und offene Fragen rund um Wirkung, Sicherheit und Forschung.
Weiterlesen
3-FPO Nachweisbarkeit: Wie lange bleibt die Substanz im Körper?
·
Wie lange bleibt 3-FPO wirklich im Körper – Stunden, Tage oder sogar Monate? Hier erfährst du alles über Blut-, Urin- und Haartests, rechtliche Folgen und warum Nachweisbarkeit nie nur eine fixe Zahl ist. Plus: sichere Alternativen aus dem Shop, die garantiert stressfrei sind.
Weiterlesen

Smartshops weltweit: Südamerika, Asien & Afrika im Fokus
·
Smartshops sind in Europa und Nordamerika längst etabliert – doch wie sieht es in anderen Teilen der Welt aus? In Südamerika, Asien und Afrika ist die Lage oft von Tradition, Religion und restriktiven Gesetzen geprägt. Dieser Guide wirft einen Blick auf die kulturellen Unterschiede, rechtlichen Rahmenbedingungen und Zukunftschancen von Smartshops weltweit.
Weiterlesen
